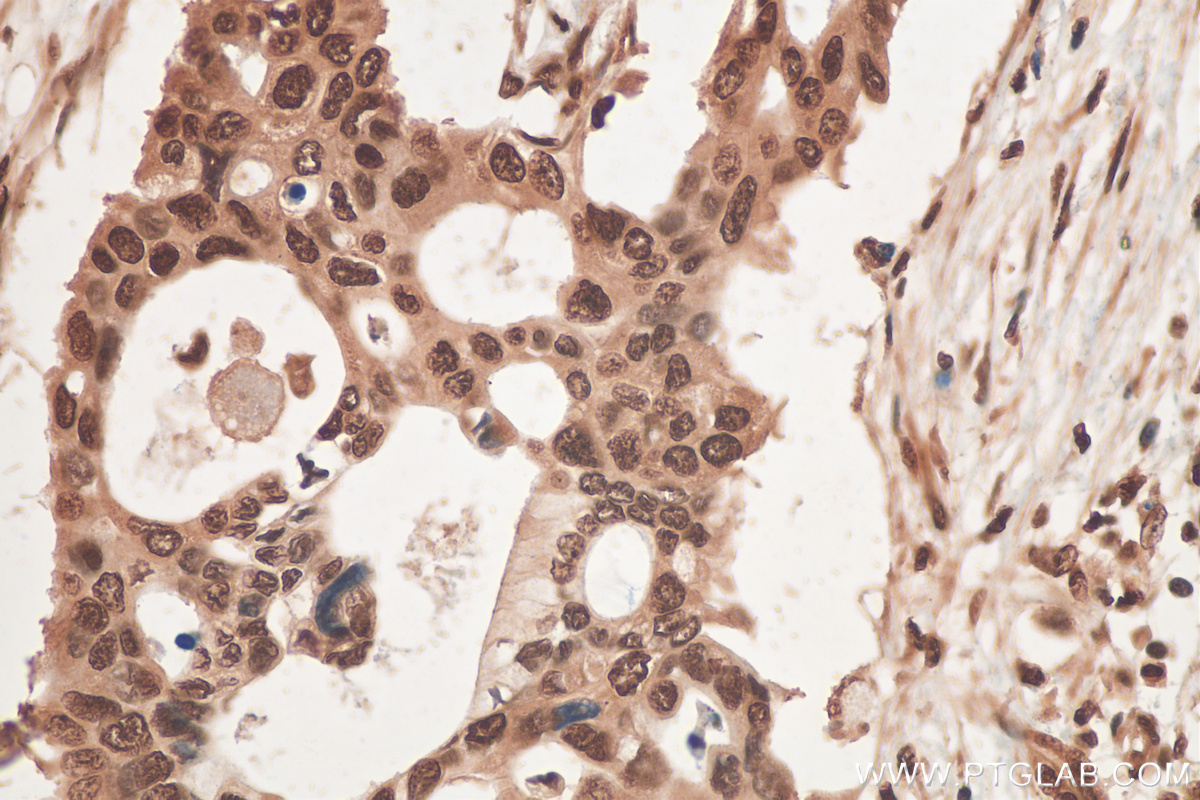

验证数据展示
经过测试的应用
| Positive WB detected in | Y79 cells, A549 cells, HEK-293 cells, HepG2 cells, PC-12 cells, PC-13 cells, mouse testis tissue, rat testis tissue |
| Positive IP detected in | HepG2 cells |
| Positive IHC detected in | human pancreas cancer tissue, human breast cancer tissue, mouse pancreas tissue Note: suggested antigen retrieval with TE buffer pH 9.0; (*) Alternatively, antigen retrieval may be performed with citrate buffer pH 6.0 |
| Positive IF/ICC detected in | HEK-293 cells |
| Positive FC (Intra) detected in | A549 cells |
推荐稀释比
| 应用 | 推荐稀释比 |
|---|---|
| Western Blot (WB) | WB : 1:2000-1:12000 |
| Immunoprecipitation (IP) | IP : 0.5-4.0 ug for 1.0-3.0 mg of total protein lysate |
| Immunohistochemistry (IHC) | IHC : 1:50-1:500 |
| Immunofluorescence (IF)/ICC | IF/ICC : 1:200-1:800 |
| Flow Cytometry (FC) (INTRA) | FC (INTRA) : 0.40 ug per 10^6 cells in a 100 µl suspension |
| It is recommended that this reagent should be titrated in each testing system to obtain optimal results. | |
| Sample-dependent, Check data in validation data gallery. | |
产品信息
10209-2-AP targets CIRBP in WB, IHC, IF/ICC, FC (Intra), IP, CoIP, RIP, ELISA applications and shows reactivity with human, mouse, rat samples.
| 经测试应用 | WB, IHC, IF/ICC, FC (Intra), IP, ELISA Application Description |
| 文献引用应用 | WB, IHC, IF, IP, CoIP, RIP |
| 经测试反应性 | human, mouse, rat |
| 文献引用反应性 | human, mouse, rat, squirrel |
| 免疫原 |
CatNo: Ag0280 Product name: Recombinant human CIRBP protein Source: e coli.-derived, PGEX-4T Tag: GST Domain: 1-172 aa of BC000403 Sequence: MASDEGKLFVGGLSFDTNEQSLEQVFSKYGQISEVVVVKDRETQRSRGFGFVTFENIDDAKDAMMAMNGKSVDGRQIRVDQAGKSSDNRSRGYRGGSAGGRGFFRGGRGRGRGFSRGGGDRGYGGNRFESRSGGYGGSRDYYSSRSQSGGYSDRSSGGSYRDSYDSYATHNE 种属同源性预测 |
| 宿主/亚型 | Rabbit / IgG |
| 抗体类别 | Polyclonal |
| 产品类型 | Antibody |
| 全称 | cold inducible RNA binding protein |
| 别名 | A18 hnRNP, A18HNRNP, CIRP |
| 计算分子量 | 172 aa, 19 kDa |
| 观测分子量 | 19 kDa |
| GenBank蛋白编号 | BC000403 |
| 基因名称 | CIRBP |
| Gene ID (NCBI) | 1153 |
| RRID | AB_2080263 |
| 偶联类型 | Unconjugated |
| 形式 | Liquid |
| 纯化方式 | Antigen affinity purification |
| UNIPROT ID | Q14011 |
| 储存缓冲液 | PBS with 0.02% sodium azide and 50% glycerol, pH 7.3. |
| 储存条件 | Store at -20°C. Stable for one year after shipment. Aliquoting is unnecessary for -20oC storage. |
背景介绍
CIRBP, also named as A18HNRNP and CIRP, is a cold-inducible mRNA binding protein that plays a protective role in the genotoxic stress response by stabilizing transcripts of genes involved in cell survival[PMID: 19158277]. CIRBP is also involved in cap-independent translation upon moderate cold-shock. It acts as a translational activator. CIRBP is a suppressive rather stimulatory effect on proliferation[PMID: 19777567]. CIRBP can translocate from nucleus to cytoplasm under stresses such as UV irradation or heat shock. Suppression of CIRBP increased the apoptotic cell population of neural stem cells at moderate low temperature[PMID: 20735994]. This antibody (Catalog# 10209-2-AP) is a rabbit polyclonal antibody raised against the full-length CIRBP of human origin.
实验方案
| Product Specific Protocols | |
|---|---|
| IF protocol for CIRBP antibody 10209-2-AP | Download protocol |
| IHC protocol for CIRBP antibody 10209-2-AP | Download protocol |
| IP protocol for CIRBP antibody 10209-2-AP | Download protocol |
| WB protocol for CIRBP antibody 10209-2-AP | Download protocol |
| Standard Protocols | |
|---|---|
| Click here to view our Standard Protocols |
发表文章
| Species | Application | Title |
|---|---|---|
Nature RBM3 mediates structural plasticity and protective effects of cooling in neurodegeneration. | ||
Cell iPSCs from a Hibernator Provide a Platform for Studying Cold Adaptation and Its Potential Medical Applications. | ||
Nat Med Cold-inducible RNA-binding protein (CIRP) triggers inflammatory responses in hemorrhagic shock and sepsis. | ||
Mol Cell Altered m6A Modification of Specific Cellular Transcripts Affects Flaviviridae Infection. | ||
Adv Sci (Weinh) Primate-Specific DAZ Regulates Translation of Cell Proliferation-Related mRNAs and is Essential for Maintenance of Spermatogonia | ||
Nucleic Acids Res Alternative splicing induced by bacterial pore-forming toxins sharpens CIRBP-mediated cell response to Listeria infection |